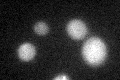
YAR073W

View description
Nonfunctional protein with homology to IMP dehydrogenase; probable pseudogene, located close to the telomere; is not expressed at detectable levels; YAR073W and YAR075W comprise a continuous reading frame in some strains of S. cerevisiae
Localization:
Intensity:
Fold change:
Significance:
-
C’ GFP library in SD

below threshold17.13 -
N' NOP1pr-GFP in SD

N/A0 -
N' TEF2pr-mCherry in SD

N/A0 -
N' NATIVEpr-GFP in SD

N/A0 -
N' TEF2pr-VC and Cyto-VN in SD

N/A0 -
C’ GFP library in SD+DTT
cytosol15.690.91No -
C’ GFP library in SD+H2O2

cytosol16.610.96No -
C’ GFP library in Starvation Media

cytosolN/AN/AYes -
C’ GFP library on the background of Pup2-DaMP

below threshold -
C’ GFP library on the background of CCT mutant

below threshold19.10531.11473No
